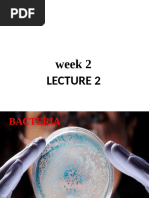

0% found this document useful (0 votes)
83 views3 pagesTypes and Growth of Bacteria Explained
Bacteria can be found almost everywhere and can survive in a wide range of temperatures. They can be autotrophic, producing their own food from inorganic substances like carbon dioxide, or heterotrophic, relying on external food sources. Autotrophic bacteria are further divided into photoautotrophic bacteria, which use light to produce food, and chemosynthetic bacteria, which produce food by oxidizing inorganic substances like hydrogen sulfide. Heterotrophic bacteria are parasitic, living off other organisms; symbiotic, living mutually beneficially with other organisms; or saprophytic, living off dead and decaying organic matter. Bacteria also differ in their oxygen requirements, being aerobic and requiring oxygen, facultatively aerobic and
Uploaded by
Vñ ÕãdCopyright
© © All Rights Reserved
We take content rights seriously. If you suspect this is your content, claim it here.
Available Formats
Download as DOCX, PDF, TXT or read online on Scribd
0% found this document useful (0 votes)
83 views3 pagesTypes and Growth of Bacteria Explained
Bacteria can be found almost everywhere and can survive in a wide range of temperatures. They can be autotrophic, producing their own food from inorganic substances like carbon dioxide, or heterotrophic, relying on external food sources. Autotrophic bacteria are further divided into photoautotrophic bacteria, which use light to produce food, and chemosynthetic bacteria, which produce food by oxidizing inorganic substances like hydrogen sulfide. Heterotrophic bacteria are parasitic, living off other organisms; symbiotic, living mutually beneficially with other organisms; or saprophytic, living off dead and decaying organic matter. Bacteria also differ in their oxygen requirements, being aerobic and requiring oxygen, facultatively aerobic and
Uploaded by
Vñ ÕãdCopyright
© © All Rights Reserved
We take content rights seriously. If you suspect this is your content, claim it here.
Available Formats
Download as DOCX, PDF, TXT or read online on Scribd